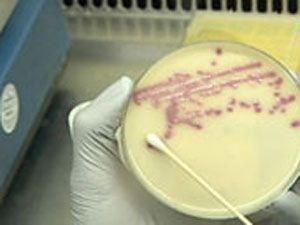
У Німеччині пік кишкової інфекції пройшов У Німеччині пік кишкової інфекції пройшов

"Існують вказівки на те, що найгірше позаду, проте ще занадто рано говорити, що все добре", — сказав він, спілкуючись з журналістами.
Експерти досі намагаються з'ясовувати, де знаходиться справжній осередок зараження. Спочатку підозри впали на огірки з Іспанії, через що сільськогосподарський сектор країни поніс величезні збитки, проте потім з'ясувалося, що центр зараження — одна з ферм поблизу Гамбурга.
З Німеччини досі надходять повідомлення про нові випадки зараження, відтак, за вівторок там було зареєстровано 94 нових випадки зараження людей гострою кишковою інфекцією.